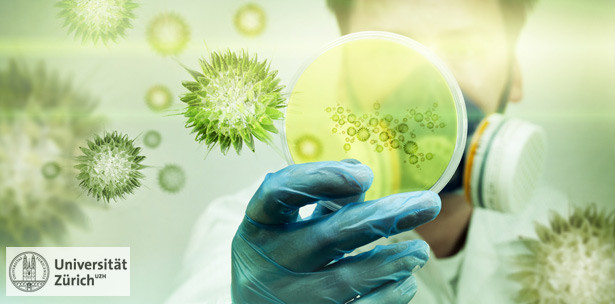
Versteckte Bakterien aufspüren

Wissenschaft und Forschung 25.11.2011
Versteckte Bakterien aufspüren
Bisher galt das Anlegen einer Bakterienkultur als einfachste Methode, um eine bakterielle Infektion nachzuweisen. Was aber tun, wenn in der Kultur keine Bakterien wachsen, der Patient jedoch ganz offensichtlich an einer bakteriellen Infektion leidet? Eine Genanalyse kann in diesen Fällen helfen, hat UZH-Mediziner Guido Bloemberg herausgefunden.
Schon manch ein Arzt sah sich mit folgender Situation konfrontiert: Der Patient weist Symptome einer bakteriellen Infektion auf, die angelegte Bakterienkultur ist jedoch negativ, das heisst, von der entnommenen Probe lassen sich keine krankmachenden Bakterien im Nährmedium vermehren. Was tun? Ohne den genauen Erreger zu kennen, verschreibt der Arzt ein Breitband-Antibiotikum in der Hoffnung, dieses wirke auch gegen das vermutete Bakterium. Oft geht dies gut, doch die Sache hat Nachteile.
Da der Arzt den genauen Erreger nicht kennt, wählt er unter Umständen nicht das genau passende Antibiotikum oder wendet es nicht genügend lange an, so dass der Patient nicht richtig gesund wird. Die Bakterienkultur, die bisher als beste Methode für den Nachweis einer bakteriellen Infektion galt, versagt offenbar in vielen Fällen. Seit einigen Jahren steht ein anderes Instrument zur Verfügung, um eine bakterielle Infektion zu diagnostizieren: die «16S rRNA Gen PCR Analyse».
Klinisch relevant
Guido Bloemberg, Leiter der Molekularen Diagnostik am Institut für Medizinische Mikrobiologie der Universität Zürich, hat die Tauglichkeit dieser Methode mit derjenigen der Bakterienkultur verglichen. Gleichzeitig hat er zeigen können, dass die 16S rRNA Gen PCR Analyse in den Fällen einer negativen Bakterienkultur zusätzliche Informationen über die Infektion des Patienten liefern kann. Die Resultate seiner Studie sind für die Arbeit in der Klinik bedeutsam und wurden in der Fachzeitschrift «Clinical Infectious Diseases» veröffentlicht.
Lesen Sie hier den vollständigen Artikel.
Quelle: UZH News, das Onlinemagzin der Universität Zürich, 25.11.2011